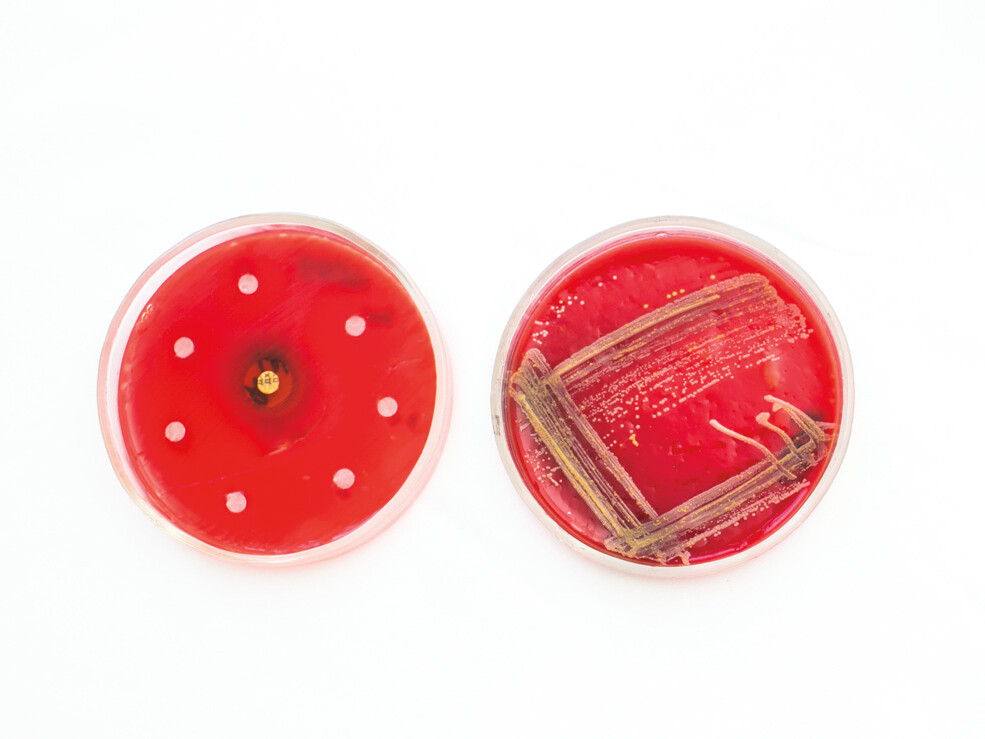
petri dishes

University in MotionFall 2016-Winter 2017
January 1, 2017
Walking time bomb
It’s an unsettling thought: You could be walking around for…
University in MotionFall 2016-Winter 2017
January 1, 2017
New entry-point
The School of Health Professions is offering one of the…
University in Motionspring/summer 2016
June 2, 2016
Healing in flight
The Army has turned to the Long School of Medicine and its…
University in Motionspring/summer 2016
June 2, 2016
Do hold your breath
A woman’s risk of long-term cardiac side effects from…
University in Motionspring/summer 2016
June 2, 2016
Only part of the story
BRCA1 is known to suppress cancer by repairing breaks in…
University in Motionspring/summer 2016
June 2, 2016
Hope for the sickest patients
University joins consortium to offer children the newest…
University in Motionspring/summer 2016
June 2, 2016
No cracking under pressure
New, stronger ceramic dental implant options are available…
University in Motionspring/summer 2016
June 2, 2016
Fighting back
The nation’s top cancer institutes unite to call for all…
University in Motionspring/summer 2016
June 2, 2016
When a skeleton fails
A key finding in Alzheimer’s disease research offers clues…
University in Motionspring/summer 2016
June 2, 2016
A pox on poxviruses
Virologists discover how poxviruses defeat the body’s…